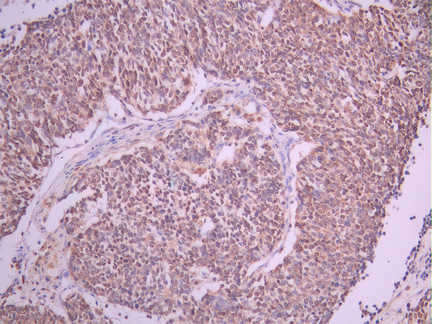

EWSR1 Recombinant Monoclonal Antibody
-
中文名稱:EWSR1 Recombinant Monoclonal Antibody
-
貨號:CSB-RA567639A0HU
-
規格:¥1320
-
圖片:
-
Western Blot
Positive WB detected in: MCF7 whole cell lysate(30μg), K562 whole cell lysate(30μg), Jurkat whole cell lysate(30μg), A431 whole cell lysate(30μg), THP-1 whole cell lysate(30μg), HEK293 whole cell lysate(30μg), U251MG whole cell lysate(30μg)
All lanes:EWSR1 antibody at 1:1000
Secondary
Goat polyclonal to rabbit IgG at 1/40000 dilution
Predicted band size: 68 kDa
Observed band size: 85 kDa
Exposure time:2min -
IHC image of CSB-RA567639A0HU diluted at 1:100 and staining in paraffin-embedded human lung cancer performed on a Leica BondTM system. After dewaxing and hydration, antigen retrieval was mediated by high pressure in a citrate buffer (pH 6.0). Section was blocked with 10% normal goat serum 30min at RT. Then primary antibody (1% BSA) was incubated at 4°C overnight. The primary is detected by a Goat anti-rabbit polymer IgG labeled by HRP and visualized using 0.05% DAB.
-
Immunofluorescence staining of HeLa cell with CSB-RA567639A0HU at 1:50 , counter-stained with DAPI. The cells were fixed in 4% formaldehyde, permeabilized using 0.2% Triton X-100 and blocked in 10% normal Goat Serum. The cells were then incubated with the antibody overnight at 4°C. The secondary antibody was Alexa Fluor 488-congugated AffiniPure Goat Anti-Rabbit IgG(H+L).
-
Overlay Peak curve showing Hela cells stained with CSB-RA567639A0HU (red line) at 1:100. The cells were fixed in 4% formaldehyde and permeated by 0.2% TritonX-100 for 10min. Then 10% normal goat serum to block non-specific protein-protein interactions followed by the antibody (1ug/1*106cells) for 45min at 4℃. The secondary antibody used was FITC-conjugated goat anti-rabbit IgG (H+L) at 1/200 dilution for 35min at 4℃.Control antibody (green line) was Rabbit IgG (1ug/1*106cells) used under the same conditions. Acquisition of >10, 000 events was performed.
-
-
其他:
產品詳情
-
Uniprot No.:
-
基因名:EWSR1
-
別名:bK984G1.4 antibody; bK984G1.4 Ewing sarcoma breakpoint region 1 protein antibody; Ewing sarcoma breakpoint region 1 antibody; Ewing sarcoma breakpoint region 1 protein antibody; Ewings sarcoma EWS Fli1 type 1 oncogene antibody; EWS antibody; EWS oncogene antibody; EWS RNA binding protein 1 antibody; EWS_HUMAN antibody; EWSR 1 antibody; Ewsr1 antibody; EWSR1 protein antibody; RNA binding protein EWS antibody; RNA-binding protein EWS antibody
-
反應種屬:Human
-
免疫原:A synthesized peptide from human EWSR1 protein
-
免疫原種屬:Homo sapiens (Human)
-
標記方式:Non-conjugated
-
克隆類型:Monoclonal
-
抗體亞型:Rabbit IgG
-
純化方式:Affinity-chromatography
-
克隆號:3F1
-
濃度:It differs from different batches. Please contact us to confirm it.
-
保存緩沖液:Rabbit IgG in 10mM phosphate buffered saline , pH 7.4, 150mM sodium chloride, 0.05% BSA, 0.02% sodium azide and 50% glycerol.
-
產品提供形式:Liquid
-
應用范圍:ELISA, WB, IHC, IF, FC
-
推薦稀釋比:
Application Recommended Dilution WB 1:500-1:5000 IHC 1:50-1:200 IF 1:50-1:200 FC 1:50-1:200 -
Protocols:
-
儲存條件:Upon receipt, store at -20°C or -80°C. Avoid repeated freeze.
-
貨期:Basically, we can dispatch the products out in 1-3 working days after receiving your orders. Delivery time maybe differs from different purchasing way or location, please kindly consult your local distributors for specific delivery time.
-
用途:For Research Use Only. Not for use in diagnostic or therapeutic procedures.
相關產品
靶點詳情
-
功能:Might normally function as a transcriptional repressor. EWS-fusion-proteins (EFPS) may play a role in the tumorigenic process. They may disturb gene expression by mimicking, or interfering with the normal function of CTD-POLII within the transcription initiation complex. They may also contribute to an aberrant activation of the fusion protein target genes.
-
基因功能參考文獻:
- ATG4B expression was observed markedly upregulated by EWS-FLI1 overexpression, and silencing of ATG4B dramatically inhibits autophagy in Ewing sarcoma cells. PMID: 28902354
- Studies demonstrate that the translocation-derived fusion protein EF (EWS-FLI1) misregulates numerous genes involved in metabolism suggesting that EF is a master regulator of metabolic reprogramming in Ewing sarcoma, diverting metabolites toward biosynthesis. PMID: 28720588
- Together, the data demonstrate the critical requirement of GGAA-microsatellites as EWS/FLI activating response elements in vivo and reveal an unexpected role for the EWS portion of the EWS/FLI fusion in binding to sweet-spot GGAA-microsatellites. PMID: 28847958
- EWSR1 fusion protein is required for PAX7 expression in Ewing sarcoma and identify a candidate EWSR1-FLI1-bound PAX7 enhancer that coincides with both a consensus GGAA repeat-containing binding site and a peak of regulatory H3K27 acetylation. PMID: 28643791
- In the 3 cases of the primary extraskeletal myxoid chondrosarcoma (EMC) of bone we found the most frequent and specific chromosomal translocation t(9:22) EWSR1-NR4A3 of the extraskeletal counterpart. PMID: 28249774
- a breakpoint in the EWSR1-ATF1 fusion to be the same as that reported in HCCC. Established CCOC-T cells grew extremely slowly, but the cells showed highly invasive activity PMID: 28559020
- study proposed that EWSR1 rearrangement was present in a subset of myoepithelial tumors of salivary glands, with variable morphological features PMID: 28648935
- EWSR1 Gene Rearrangement is associated with Endometrial Primitive Neuroectodermal Tumor. PMID: 28801375
- -cell lymphoblastic leukemia with t(11;22)(q24;q12) and EWSR1 rearrangement. PMID: 28104675
- Kinetics of EWSR1 fusion sequence copy numbers in the plasma are correlated with changes of the tumor volume in patients with localized and metastatic disease. PMID: 27283964
- Authors found that FUS, EWS and TAF15 expression is differentially regulated during brain development, both in time and in space. In particular, this study identifies a fine-tuned regulation of FUS and EWS during neuronal differentiation. PMID: 28453628
- Recent advances in biologic and genomic understanding of these two cancers has expanded the potential for therapeutic advancement and prevention. In Ewing sarcoma, directed focus on inhibition of EWSR1-FLI1 and its effectors has produced promising results. PMID: 28561686
- data suggest EWS/FLI binds to "promoter-like" and "enhancer-like" microsatellites to mediate activation and repression of target genes through different regulatory mechanisms PMID: 29091716
- As spontaneous fluctuations in EWS-FLI1 levels of Ewing sarcoma cells in vitro and in vivo, associated with a switch between a proliferative, non-migratory EWS-FLI1-high and a non-proliferative highly migratory EWS-FLI1-low state, were recently described, our data provide a mechanistic basis for the underlying EWS-FLI1-dependent reversible cytoskeletal reprogramming of Ewing sarcoma cells. PMID: 28671673
- Fusion of short fragments of EWSR1 to FLI1 is sufficient to recapitulate BAF complex retargeting and EWS-FLI1 activities; studies thus demonstrate that the physical properties of prion-like domains can retarget critical chromatin regulatory complexes to establish and maintain oncogenic gene expression programs. PMID: 28844694
- Case Reports: maxillary sinus clear cell carcinomas with EWSR1-ATF1 gene fusion. PMID: 27916624
- Results expand the spectrum of tumor types harboring EWSR1/FUS-ATF1 gene fusions to include a subgroup of conventional epithelioid malignant mesothelioma. PMID: 28505004
- papillary thyroid carcinomas with EWSR1 rearrangement disclosed a lower percentage of nuclei with EWSR1 polysomy than those without EWSR1 rearrangement PMID: 28236059
- The net result of combined lurbinectedin and irinotecan treatment was a complete reversal of EWS-FLI1 activity and elimination of established tumors in 30% to 70% of mice after only 11 days of therapy. Our results illustrate the preclinical safety and efficacy of a disease-specific therapy targeting the central oncogenic driver in Ewing sarcoma. PMID: 27697767
- Aggregation of FET proteins FUS, EWSR1, and TAF15 mediate a pathological change in amyotrophic lateral sclerosis. (Review) PMID: 27311318
- A subgroup of MAML2 fusion-negative mucoepidermoid carcinomas are actually clear cell carcinoma of the salivary gland with EWSR1 translocation. PMID: 27769871
- Study found consistent DNA hypomethylation at enhancers regulated by the disease-defining EWS-FLI1 fusion protein, thus establishing epigenomic enhancer reprogramming as a ubiquitous and characteristic feature of Ewing sarcoma. PMID: 28134926
- Report a distinct group of myxoid mesenchymal neoplasms occurring in children or young adults with a predilection for intracranial locations with EWSR1-AFT1/CREB1/CREM fusions. PMID: 28009602
- We conclude that in the context of 22q11-12 regional alterations present in SMARCB1-deleted tumors, simultaneous EWSR1 involvement may be misinterpreted as equivalent to EWSR1 rearrangement. A detailed clinicopathologic correlation and supplementing the EWSR1 FISH assay with complementary methodology is mandatory for correct diagnosis PMID: 27218413
- While our study confirmed that fluorescence in-situ hybridization is a sensitive and specific tool in the diagnosis of EWSR1-associated tumours, atypical fluorescence in-situ hybridization signals and classical rearrangement in entities other than EWSR1-associated tumours can occur PMID: 27385661
- EWSR1 regulates the acetylation of microtubules in a cell cycle-dependent manner through its dynamic location on spindle MTs, and may be a novel regulator for mitosis progress independent of its translocation. PMID: 27341063
- Studies provide evidence that FUS/TLS, EWS and TAF15 proteins play a major role in neurodegenerative disorders. (review). PMID: 27415968
- We identified EWSR1 rearrangement in 25% of Ectomesenchymal chondromyxoid tumour PMID: 27010880
- EWSR1-related rearrangement was detected extraskeletal myxoid chondrosarcoma PMID: 27402218
- a novel EWSR1/ETS chimeric gene, was identified in a patient diagnosed with refractory AML, suggesting a potential role of leukemogenesis in rare cases of AML. This fusion gene is very likely to exhibit oncogenic potential by interfering with the p53/p21-dependent pathway. PMID: 27627705
- LRWD1 is a novel regulator of EWS-FLI1 driven cell proliferation in Ewing sarcoma cells. EWS-FLI1 regulates LRWD1 expression and LRWD1 may contribute to EWS-FLI1 mediated transcriptional repression. PMID: 27760381
- Ewing sarcoma may be susceptible to treatment with epigenetic inhibitors blocking BRD3/4 activity and the associated pathognomonic EWS-FLT1 transcriptional program. PMID: 26623725
- FUS and EWS target genes involved in pathways at the RNA regulatory level PMID: 26573619
- Identify SP1 and PI3K/AKT signaling as modulators of EWS/FLI1 gene expression in tumor cell lines. PMID: 26336820
- Case Reports: 2 girls with primary renal myoepithelial carcinomas with a novel EWSR1-KLF15 fusion. PMID: 26523541
- 3'-UTR poly(T/U) repeat of EWSR1 is altered in microsatellite unstable colorectal cancer. PMID: 25930744
- study investigated EWSR1 status in ovarian hemangiomas; all cases were negative for EWSR1 rearrangement; 2 cases demonstrated additional intact copies of EWSR1 indicating aneusomy 22 or structural abnormality of chromosome 22 resulting in apparent duplication of the EWSR1 gene region PMID: 25851709
- The paper investigates the presence of EWS/FLI-1 fusion in clinically diagnosed sarcoma belonging to different non-Ewing connective tissue tumors. PMID: 25914746
- Results show that RNA-binding protein EWS binds and regulates CCDC6 expression at RNA and protein levels. PMID: 25751255
- KLF17 is also a rare gene fusion partner to EWSR1-rearranged myoepithelial tumors. PMID: 25706482
- The impairment of EWS-dependent midzone formation via the recruitment of Aurora B is a potential mechanism of Ewing sarcoma development. PMID: 25483190
- Results show that although the cosegregation of the EWSR1 p.R471C substitution in the index family could not be established in people suffering from essential tremor, the EWSR1 p.R471C substitution is a candidate variant that needs to be further screened. PMID: 25375143
- A key function of EWS-FLI1 in tumorigenesis is to maintain the epigenetic memory of activated homeobox genes programs. PMID: 25625846
- Data suggest that aberrant cell cycle activation in Ewing sarcoma is due to the de-repression of transcription factor E2F targets of transcriptional induction and physical recruitment of E2F3 by fusion protein EWS-FLI1 replacing E2F4 on their promoters. PMID: 25712098
- EWS/FLI-induced repression of alpha5 integrin and zyxin expression promotes tumor progression by supporting anchorage-independent cell growth. PMID: 25057021
- These experiments establish systemic alternative splicing as an oncogenic process modulated by EWS-FLI1. PMID: 25737553
- Case Reports: genetically confirmed primary renal sclerosing epithelioid fibrosarcoma with EWSR1-CREB3L1 gene fusion. PMID: 25353281
- Describe EWSR1 gene rearrangement in a subset of myoepithelial carcinomas arising in minor and major salivary glands. PMID: 25581728
- EWSR1-ATF1 fusion gene was found in hyalinizing clear cell carcinoma PMID: 25359601
- EWSR1 rearrangement is associated with ewing sarcomas. PMID: 24293381
顯示更多
收起更多
-
相關疾病:Ewing sarcoma (ES); Angiomatoid fibrous histiocytoma (AFH)
-
亞細胞定位:Nucleus. Cytoplasm. Cell membrane. Note=Relocates from cytoplasm to ribosomes upon PTK2B/FAK2 activation.
-
蛋白家族:RRM TET family
-
組織特異性:Ubiquitous.
-
數據庫鏈接:
Most popular with customers
-
-
YWHAB Recombinant Monoclonal Antibody
Applications: ELISA, WB, IHC, IF, FC
Species Reactivity: Human, Mouse, Rat
-
Phospho-YAP1 (S127) Recombinant Monoclonal Antibody
Applications: ELISA, WB, IHC
Species Reactivity: Human
-
-
-
-
-